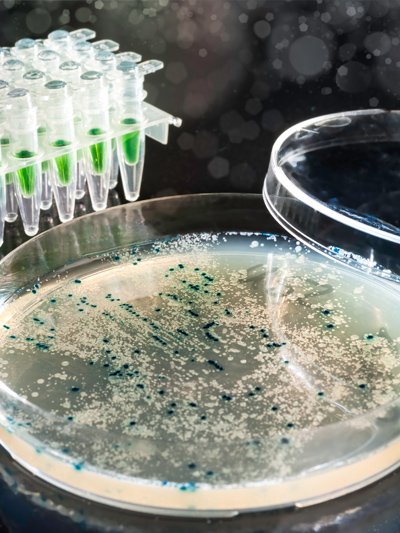

HU-10 頂級超濾型淨水組
‧ 醫療級雙重濾心過濾,安全無虞
‧ 配備 HONEYWELL 原廠智慧龍頭,水質安全監控
| HU-10 頂級超濾型淨水組 產品規格 | |
|---|---|
| 適用水壓 | 2 ~ 6 Bar |
| 適用溫度 | 5℃ ~ 40℃ |
| 最大流量 | 1.5L / min |
| 總處理量 | 4000 L |
| 過濾孔徑 | 0.04 微米 |
| 尺 寸 | 高32 x 寬23 x 深11.5 CM |
產品特性以及用途:

泥沙、雜質

硬水、水垢

餘氯、有機汙染

細菌、病毒

HONEYWELL 淨水組系列

內建微細濾膜、壓縮活性碳棒
有效去除水中顆粒雜質、懸浮微粒
有效去除餘氯、三鹵甲烷、鉛等有害物質
添加抑菌成分,防止濾心及龍頭細菌孳生


採用0.04微米超濾中空絲膜(醫療級)
有效阻絕細菌、病毒、微生物
保留人體所需的礦物質和微量元素
提升口感,確保飲水衛生及健康

科技質感智慧龍頭
打開龍頭時,龍頭上的背光屏以漸亮的方式顯示淨水器狀態,方便、美觀。

濾心狀態安全監控
當龍頭上的背光屏顯示黃燈或紅燈時,可透過控制盒上的指示燈準確辨別需要更換的濾心。

漏水偵測保護裝置
智能型漏水斷路偵測器,保護室內裝潢及設備安全。
幫助您實現呵護家人身體健康的願望
大家都想杜絕頻繁的水汙染事件,但這不是一個人一天可以完成的。如果您想改善自己家裡的用水環境,這恰好是您立即就能解決的。Honeywell家居用水系統,為您提供前置過濾器、中央淨水機、軟水機到多款末端淨水組的全系列水處理商品,提升水的品質、幫您實現呵護家人身體健康的願望。
HONEYWELL 提升家的品質
Honeywell成立於1885年,至今已有近130年歷史,是一家集航太科技、環境控制、交通系統和特殊材料四大業務於一身的多元化全球企業。Honeywell目前在全球95個國家,擁有83個分公司,其中包含台灣,2012年銷售額達370億美元,是世界前500強企業。
全球超過1.5億家庭正在使用Honeywell提供的服務與產品,從家居用水、室內空氣品質到家居地暖系統,Honeywell憑藉其領先的技術和優質產品,為這些家庭提供更安全、更舒適、更節能的環境。


更多相關淨水設備 Relate Products
Copyright © 2017 寬碩實業有限公司. All rights reserved. Terms of Use | Privacy Policy









